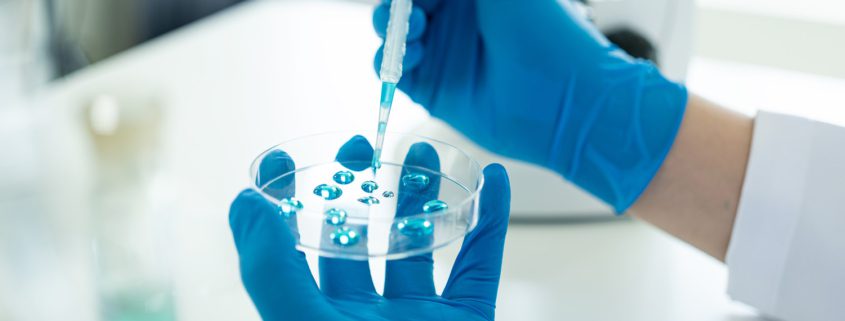

Global Trade Flows and Demand Outlook for the Life Sciences in 2026
Strategic Positioning in a Fragmented but Expanding Global Economy
As 2026 begins, global trade in life sciences is navigating a mixed environment of resurgent demand, regional fragmentation, and shifting sourcing strategies. For pharmaceutical, biotech, and medical device companies, this landscape presents both new opportunities and operational risks. Understanding where demand is accelerating, which regions are becoming more self-reliant, and how trade flows are evolving is essential for resilient logistics planning.
Growth Hotspots in Life Sciences Trade
The strongest growth in pharmaceutical and biotech demand in 2026 is projected in:
- India: 8.2% YoY growth driven by domestic consumption and government incentives for manufacturing and R&D.
- Southeast Asia: Vietnam, Indonesia, and the Philippines are rapidly scaling healthcare infrastructure and consumption.
- GCC Region (Saudi Arabia, UAE): Significant investments in biologics, vaccine manufacturing, and pharma free zones.
- Latin America: Brazil and Mexico continue to be major importers of finished pharma goods and devices, with growing local manufacturing capability.
As these markets grow, they are also diversifying import sources, reducing reliance on singular countries such as China, and seeking multi-country supply chain footprints for critical medicines and inputs.
U.S. Trade Dynamics with Key Partners
The United States remains a top export destination for Indian and EU pharmaceutical products. U.S. exports of medical technology, diagnostics, and clinical materials also continue to grow, particularly toward:
- Latin America
- Middle East & North Africa
- Southeast Asia
However, compliance expectations (FDA, CBP, EU MDR, etc.) and rising scrutiny around dual-use goods and sanctions are making customs clearance and documentation more complex—especially in trade with China, Russia, and Iran.
Fragmentation and Trade Bloc Strategies
2026 is seeing further entrenchment of regional trade blocs:
- RCEP (Asia) is facilitating smoother intra-Asian supply chain movement.
- EU–India trade talks and U.S.–ASEAN supply chain frameworks are encouraging near-sourcing and regionalization.
- China+1 sourcing continues, with companies diversifying into Malaysia, India, and Vietnam.
For life sciences firms, these shifts mean greater complexity but increased optionality. Strategic trade lane mapping, diversified sourcing, and agile logistics partners are more vital than ever.
How Euro-American Worldwide Logistics Helps You Navigate Global Trade Shifts
At Euro-American, we help clients stay ahead of global trade trends with:
- Country-specific import/export expertise across key regions including India, Southeast Asia, and Latin America
- In-house Customs Brokerage services, including product classification, license support, and CBP/FDA clearance
- Real-time trade lane optimization and geopolitical risk monitoring
- Integrated compliance solutions for navigating dual-use goods, cold chain regulations, and documentation across regions
- Seamless coordination with overseas agents to mitigate delays and disruptions
Our 60-year legacy and deep focus on the life sciences allow us to provide tailored logistics solutions that respond to evolving trade flows—and support your growth into high-opportunity markets with confidence. Contact us today.
References
World Trade Organization. “Global Trade Outlook and Statistics 2026.”
IMF World Economic Outlook, Q4 2025.
USTR: “2025 Pharmaceutical and Medical Device Trade Update.”
Economist Intelligence Unit. “Regional Trade Blocs and Supply Chain Rewiring.”
India Ministry of Commerce. “Pharma Exports and Growth Trends FY2025.”